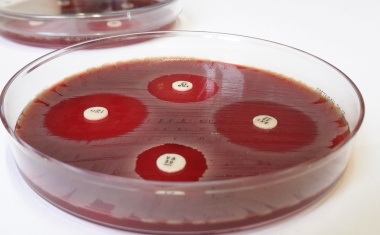
Photo

Unheilvoller Fehlalarm in der Niere
Bonner Forschende enthüllen, wie ein winziges RNA-Molekül in der Niere eine tödliche Autoimmunerkrankung auslöst.

Bonner Forschende enthüllen, wie ein winziges RNA-Molekül in der Niere eine tödliche Autoimmunerkrankung auslöst.

Neue Forschung zeigt: Kombination aus sNfL und cTnT ermöglicht genauere Unterscheidung zwischen ALS und anderen neurodegenerativen Erkrankungen.

Die Experten unterstützen das Bundesinstitut für Arzneimittel und Medizinprodukte bei besonderen Verfahren.

Die Medizinische Fakultät der Universität Bonn hat der international renommierten Wissenschaftlerin Prof. Sharon Lewin die Ehrendoktorwürde verliehen.

Depressionen betreffen 280 Millionen Menschen weltweit. Eine Depressionserkrankung führt erwiesenermaßen zu verändertem Essverhalten.

Die genetische Sicherung der Verdachtsdiagnose „Erblicher Darmkrebs“ hat große Bedeutung für die medizinische Versorgung der betroffenen Familien. Aber viele der in den bekannten Genen identifizierten Varianten können bisher hinsichtlich ihrer ursächlichen Rolle bei der Tumorbildung noch nicht sicher eingeordnet werden.

Dr. Simon Haas von der Charité-Universitätsmedizin Berlin erhielt nun den Lisec-Artz-Preis. Die Auszeichnung fand während der Cluster Science Days des Exzellenzcluster ImmunoSensation2 der Universität Bonn statt.

Die EU stellt Mittel für die Erforschung tödlicher Blutvergiftung zur Verfügung.

Kooperation aus Uni Bonn, den USA und den Niederlanden knackt die Wirkweise des Clovibactins.

Die Relios.Vision GmbH, ein Start-up aus der Klinik für Neuroradiologie des Universitätsklinikums Bonn (UKB) und dem Institut für Angewandte Mathematik der Universität Bonn, das die SmartContrast Software entwickelt hat, wurde für das WomenTechEU Programm des European Innovation Council (EIC) ausgewählt.

Internationale Forschungsgruppe identifiziert ein vielversprechendes Gerüst für antimikrobielle Mittel.

Beschäftigte im Gesundheitswesen waren und sind durch die Covid-19-Pandemie schwer belastet. Welche Schutzfaktoren helfen können, mit diesen Belastungen umzugehen, zeigt nun eine Studie der Universität Bonn.

Die Universitäten Bonn und Tübingen beteiligen sich an weltweiter Aktionswoche.